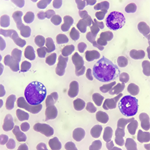

The PAMJ CM Images provides quick access to images published in the PAMJ Clinical Medicine. Images are submitted by clinical practitioners around the world to share unique clinical features for knowledge sharing and medical practice and training. Images in clinical Medical are published and under the terms of the Creative Commons Attribution 4.0 International (CC BY 4.0).
Tolosa-hunt syndrome: unraveling painful ophthalmoplegia through imaging
Devyansh Nimodia, Pratapsingh Hanuman Parihar
PAMJ-CM. 2025; 19: 13. Published 03 November 2025
Exostosis of distal femur: benign bone tumor
Aishwarya Borhade, Pratik Phansopkar
PAMJ-CM. 2025; 19: 11. Published 24 October 2025
Isolated fallopian tube torsion in pediatric age: a serious cystadenoma presented as a twisted hydrosal-pinx
Balde Fatoumata Binta, Bouabdallah Youssef
PAMJ-CM. 2025; 19: 9. Published 22 September 2025
Colobome palpébral supérieur
Seydou Diallo
PAMJ-CM. 2025; 18: 6. Published 20 June 2025
Graves' acropachy in an euthyroid patient
Gabriel Canhete Machado, Letícia Schwerz Weinert
PAMJ-CM. 2025; 18: 4. Published 17 June 2025
Reemergence of tuberculosis with adrenal and cutaneous manifestations 12 years after declared cure
Meryam Alahyane, Nawal El Ansari
PAMJ-CM. 2025; 17: 22. Published 05 March 2025
Clinical characteristics of 46,XX male with congenital adrenal hyperplasia in Morocco
Meryam Alahyane, Nawal El Ansari
PAMJ-CM. 2025; 17: 19. Published 20 February 2025
Type I Arnold Chiari malformation with an accompanying bifid spinous process at the C3 vertebra in a 19-year-old female
Aditi Pradip Ambekar, Sharath Hullumani
PAMJ-CM. 2025; 17: 18. Published 18 February 2025
Amyand's hernia: an uncommon encounter of the appendix in an inguinal hernia
Devesh Nagpure, Sheetal Asutkar
PAMJ-CM. 2025; 17: 11. Published 31 January 2025
Burkitt´s lymphoma: clinical image of a rare but nasty cancer
Rachid Douge
PAMJ-CM. 2025; 17: 9. Published 27 January 2025
Faux anévrisme axillaire post-traumatique
Zakaria Zoheir Addou, Djamila-Djahida Batouche
PAMJ-CM. 2025; 17: 4. Published 15 January 2025
Very early mitral valve thrombosis
Abdelilah Benbihi, Mohamed Messouak
PAMJ-CM. 2024; 16: 11. Published 23 September 2024
Tumeur à cellules géantes des membres inférieurs
Kaba Condé, Fodé Abass Cissé
PAMJ-CM. 2024; 16: 9. Published 21 September 2024
Pseudo-duplication du nerf optique et colobome choriorétinien
Seydou Diallo
PAMJ-CM. 2024; 16: 8. Published 21 September 2024
Déchirure post-coïtale révélant un syndrome de Rokitansky
Dhekra Toumi, Imen Ben Farhat
PAMJ-CM. 2024; 16: 3. Published 12 September 2024
| Articles published in PAMJ-CM are Open Access and distributed under the terms of the Creative Commons Attribution 4.0 International (CC BY 4.0). |  |

eISSN: 2707-2797
The PAMJ Clinical Medicine (ISSN: 2707-2797) is a subsidiary of the Pan African Medical Journal. The contents of this journal is intended exclusively for professionals in the medical, paramedical and public health and other health sectors.
Currently tracked by: DOAJ, AIM, Google Scholar,
Physical address: Kenya: 3rd Floor, Park Suite Building, Parkland Road, Nairobi. PoBox 38583-00100, tel: +254 (0)20-520-4356 | Cameroon: Immeuble TechnoPark Essos, Yaounde, PoBox: 10020 Yaounde, tel: +237 (0)24-309-5880